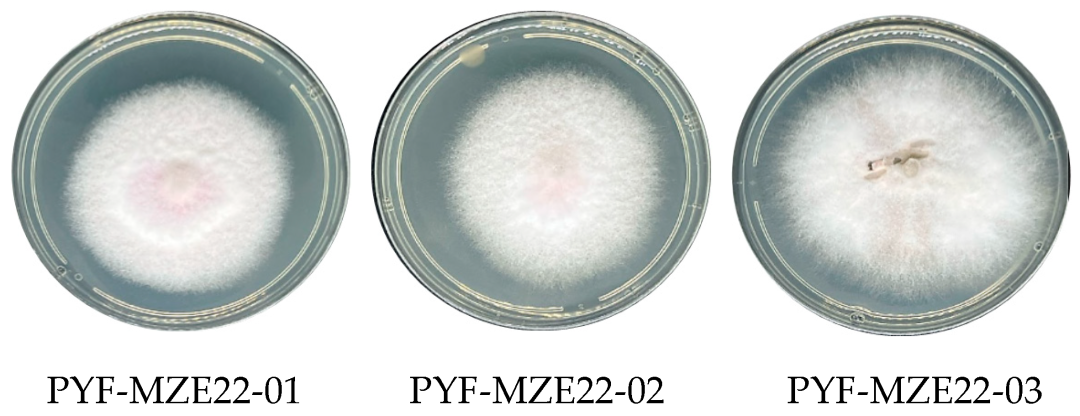

Confirman presencia de peligroso hongo en cultivos de maíz en Paraguay
El cultivo de maíz (Zea mays L.) es un pilar para la seguridad alimentaria nacional y una fuente vital para la producción. Con más de
Líderes en innovación, proyectos, publicaciones y centros de desarrollo científico tecnológico en Paraguay, generando soluciones que atiendan las necesidades prioritarias del país en lo social, económico, político ambiental y cultural.
522
Lineas de Investigación
1.824
Artículos Científicos, según Scopus
361
Investigadores Categorizados PRONII
59
Docentes Investigadores de Dedicación Completa
El cultivo de maíz (Zea mays L.) es un pilar para la seguridad alimentaria nacional y una fuente vital para la producción. Con más de

Una delegación conformada por 50 investigadores e innovadores de las 14 unidades académicas de la Universidad Nacional de Asunción (UNA) -tanto de las sedes centrales,

La Dirección General de Investigación Científica y Tecnológica de la Universidad Nacional de Asunción (DGICT-UNA) llevó adelante talleres orientados a mejorar las capacidades de jóvenes

Autoridades de la Universidad Nacional de Asunción (UNA) se reunieron con representantes de la Agencia de Cooperación Internacional de Corea (KOICA), el pasado 20 de

La Prof. Dra. Zully Vera de Molinas, rectora de la Universidad Nacional de Asunción (UNA), recibió la visita del Dr. Kyoung-il Kim, científico principal de

El Consejo Nacional de Ciencia y Tecnología (CONACYT) realizó un acto de cierre del Programa de Innovación en Empresas Paraguayas (PROINNOVA) el miércoles 17 de